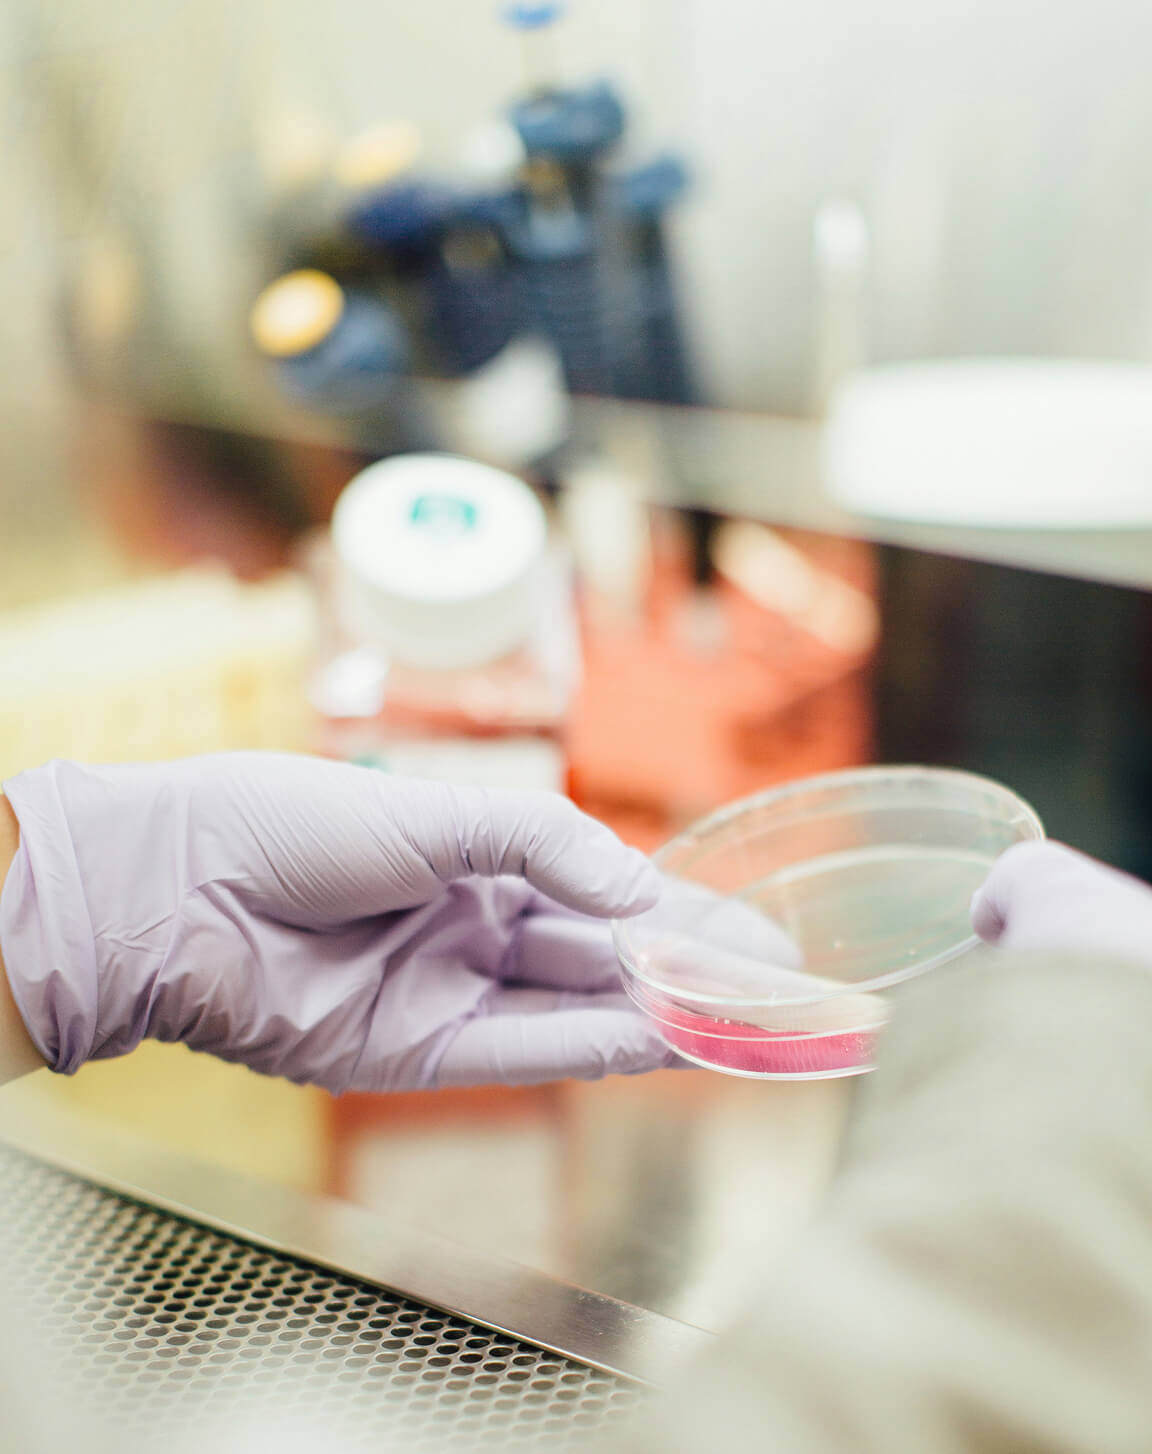

Our Impact
Our funded research projects are actively contributing to improved outcomes for individuals battling breast cancer, redefining the concept of a cure. This includes advancements in more humane treatments, early detection methods, enhanced diagnosis and prognosis, precise therapies, and an overall improvement in the quality of life and survival, with a dedicated focus on enhancing equity.


We exist for a Breast Cancer Cure
We have been at the forefront of funding impactful and innovative breast cancer research in New Zealand for over 29 years. Throughout the past three decades, our dedicated breast cancer researchers have initiated world-class projects aimed at improving outcomes for those battling this disease.
You can do something powerful.
There are many ways to support research into a breast cancer cure, from attending inspiring events and making one-off or regular donations, to choosing monthly giving for ongoing impact. You can also become a Patron, leave a legacy in your Will, give in celebration of a special occasion, or use Payroll Giving to donate directly from your pay with immediate tax benefits, helping fund vital research and make a lasting difference for New Zealanders.
Donate
Become a Patron
Help Fund Life-Saving Research.
Your support helps accelerate breast cancer research in New Zealand, giving our scientists the resources they need to find answers faster.
Together for a Cure
Love events and fashion? Be a part of something truly special. Join our volunteer team and help support life-saving breast cancer research.




"When people come together with a shared purpose, they create the power to change the future for generations of New Zealanders."
To protect the ones we love
We’re for the next generation. Only research will find a cure. We fund vital breast cancer research in Aotearoa New Zealand.
CURE
FOR A
Researching